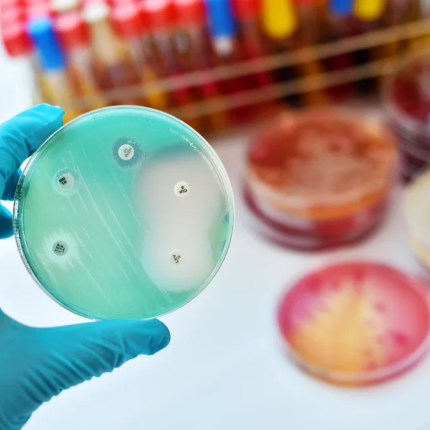
βακτηριο

Χάρη στην τεχνητή νοημοσύνη
ΑΝΤΙΒΙΟΤΙΚΟ
Body
Απογοητευτικά είναι νέα ευρήματα για ένα αντιβιοτικό ευρείας χρήσης που είχε συμπεριληφθεί στα θεραπευτικά σχήματα κατά της COVID-19
Body
Πόσο αποτελεσματικό είναι το νέο αντιβιοτικό
Body
Ένας άνδρας στη Βρετανία, ο οποίος έχει κολλήσει γονόρροια, είναι ο πρώτος...
Body
Σε περίπτωση που δεν το γνωρίζατε, τα κρεμμύδια αποτελούν μια από τις καλύτερες φυσικές θεραπείες για διάφορα προβλήματα
Ράδιο Κρήτη © | 2013 -2026
ekriti.gr
Όροι Χρήσης
|
Ταυτότητα
Designed by
Cloudevo, developed by
Pixelthis